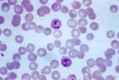

: CILIADO
: CILIADO
 : FLAGELADO
: FLAGELADO
 : RIZÓPODOS
: RIZÓPODOS
: ESPOROZOOS
: ESPOROZOOS
 : CILIADO
: CILIADO
Otros juegos similares:
Otros juegos similares:
Otros juegos similares:






















